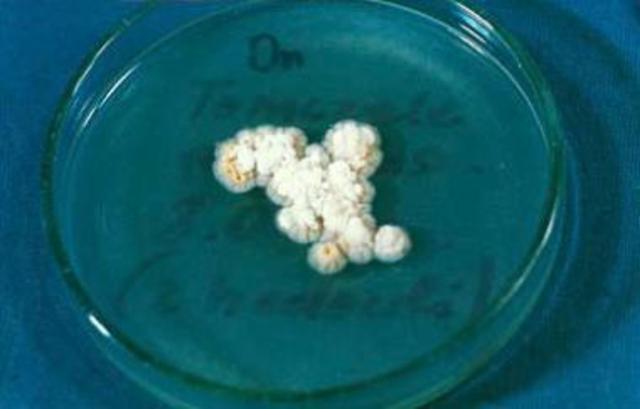
estudio del hongo favus

-
Pintura mural de la tumba del faraón de la XII dinastía, Amenemhet: su representación era de una nueva fuente nutricional http://carlitosber.blogspot.com/2016/06/historia-del-arte-7.html
-
En 1590 Fue el primero en estudiar tejidos vivos al microscopio
-
 1668 un microscopio simple pero mejorado, que puede enfocar hasta 200 veces el tamaño.
1668 un microscopio simple pero mejorado, que puede enfocar hasta 200 veces el tamaño. -
-
Inicia con SHOENLEIN
http://emedicine.medscape.com/article/1090828-workup -
lo realiza VANDICK CARTER
http://www.conganat.org/seap/reuniones/almagro2000/casas/infecg7.htm -
RAYMOND SABOURAND
http://iammapchapter.blogspot.com/2011/11/raymond-sabouraud.html -
BUSSE Y BUSCHKE habla sobre esto https://en.wikipedia.org/wiki/Cryptococcosis
-
la realiza SAMUEL TAYLOR DARLING
https://es.wikipedia.org/wiki/Histoplasmosis -
ALEXANDER FLEMMING
https://es.wikipedia.org/wiki/Penicilina -
JORGE LOBO
https://es.wikipedia.org/wiki/Lobomicosis -
Lo hace WHITTAKER
http://www.bioenciclopedia.com/reino-fungi/
Plan projects on a visual timeline
Map milestones, phases, deadlines, and key events in one place so the sequence is easier to see and share. Timetoast is a timeline maker for work, school, research, and stories.